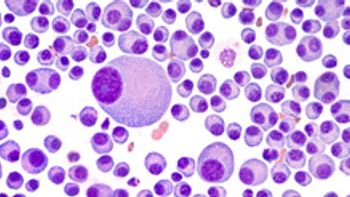

This year's most-read cancer news included researchers finding a possible liver cancer immunotherapy, cancer patients facing many negative impacts from COVID-19 and more.

This year's most-read cancer news included researchers finding a possible liver cancer immunotherapy, cancer patients facing many negative impacts from COVID-19 and more.

Lunsumio is Genentech’s first approved T-cell engaging bispecific antibody and targets CD20 on the surface of B cells and CD3 on the surface of T cells.

The combination includes an antibody-drug conjugate with an immunotherapy to treat patients with advanced bladder cancer. The PDUFA action date is April 21, 2023.

Rezlidhia is an oral, small molecule inhibitor of mutated IDH1 that was approved by the FDA to treat patients with relapsed or refractory acute myeloid leukemia.

Researchers modeling the cost-effectiveness of chimeric antigen receptor T-cell therapy (CAR-T) therapy and antibody conjugate found that they fell short.

Cytalux, approved in November 2021 for identifying ovarian cancer lesions, is now approved to spot lung cancer during surgery.

Adstiladrin offers an alternative to bladder removal surgery for patients who are at high risk of recurrence and metastatic cancer.

HyBryte is a photodynamic therapy. The active ingredient, synthetic hypericin, is topically applied to skin lesions that is taken up by the malignant T-cells and activated by visible light.

The agency has extended the review time by three months for Lynparza in combination with abiraterone and prednisone or prednisolone.

Moderna is developing an individualized cancer vaccine that uses mRNA technology to specifically target that person’s cancer.

Magellan Rx predicts oncology and high-cost rare disease treatments will continue to drive medical pharmacy spend in commercial, Medicaid and Medicare.

The FDA issued an accelerated approval for Mirati’s Krazati for patients with KRAS-mutated non-small cell lung cancer. The agency also approved a companion diagnostic to identify eligible patients.
Talquetamab is a bispecific antibody that targets both CD3 on T cells and GPRC5D, which is overexpressed on myeloma cells.

Oncopeptides disagrees with the FDA about Pepaxto and will make a decision about next steps by the end of the first quarter of 2023.

The researchers have several suggestions for how harm from screening should be reported in screening guidelines.

In October, an FDA advisory committee voted against omburtamab, saying the trials didn’t show evidence that the therapy improves overall survival.

I/Ontak is an engineered IL-2-diphtheria toxin fusion protein. The PDUFA target action date is Sept. 28, 2023.

Doctors surveyed by the Association for Clinical Oncology said payer prior authorization can cause disease progression and loss of life.

A confirmatory trial of Tecentriq in urothelial carcinoma failed to meet the co-primary endpoint of overall survival.

An advisory committee had voted against poziotinib to treat patients with non-small cell lung cancer with HER2 exon 20 insertion mutations.

In this final video of a three-part video series, Oncologist and Vice President of Medical Affairs at Quest Diagnostics, Dr. Yuri Fesko, shares a key takeaway from Quest's recent Health Trends Survey. Results reveal how cancer diagnosis numbers are still lagging to pre-pandemic levels of 11%. Fesko adds that bringing cancer screenings to the community can increase diagnosis numbers, leading to care sooner.

Dr. Yuri Fesko of Quest Diagnostics says the "pathways approach" helped one health system speed the time between diagnosis and targeted treatment for lung cancer by as much as a month for some patients. This is the second part of a three-part video series.

A confirmatory trial in patients with relapsed or refractory multiple myeloma did not meet its primary endpoint of progression-free survival.

If approved, epcoritamab would be the first bispecific antibody to treat adult patients with relapsed/refractory large B-cell lymphoma. The Prescription Drug User Fee Act date is May 21, 2023.

Rylaze’s dosing options provide sustained asparaginase activity throughout the entire course of treatment for adult and pediatric patients with acute lymphoblastic leukemia or lymphoblastic lymphoma.